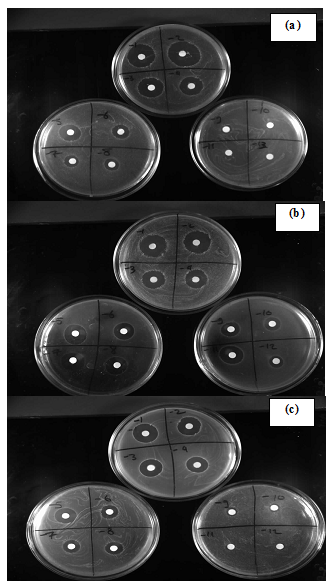

1Department of Pharmaceutics and Industrial Pharmacy, College of Pharmacy, Cairo University, Egypt, 2Department of Pharmaceutics and Industrial Pharmacy, College of Pharmacy, Misr University for Science and Technology (MUST), Giza, Egypt.
Email: dr.menna412@yahoo.com
Received: 24 Aug 2014 Revised and Accepted: 25 Sep 2014
ABSTRACT
Objectives: To investigate and evaluate the transdermal delivery of ethosomes bearing vancomycin hydrochloride, a glycopeptide antibiotic with a relatively high molecular weight (1485.7Da).
Methods: Vancomycin loaded ethosomes were prepared by cold method technique and characterized for vesicular shape, vesicular size, entrapment efficiency, zeta potential, in vitro drug permeation, microbiological assay against methicillin resistant Staphylococcusaureus (MRSA) and stability.
Results: Microscopic examinations suggested ethosomes as unilamellar spherical vesicles. Vesicle size, entrapment efficiency and zeta potential values were depending on concentration of membrane components. Ethosomal formula having 1% phospholipid, 45% ethanol and 10% propylene glycol (F13) showed the smallest mean particle size (71.60nm±17.6) and highest transdermal flux (414.7 µg/cm2. hr) across hairless rat skin which was 72.67 times drug solution. The results obtained from microbiological assay suggested that the minimum inhibitory concentration (MIC) is affected by surface charge of ethosomes. The optimized formula on storage at 4°C for 90 days retained 89.82%±1.00 of initial drug content.
Conclusions: The results collectively suggest that ethosomes are efficient carrier for transdermal delivery of vancomycin hydrochloride.
Keywords: Transdermal, Ethosomes, vancomycin hydrochloride.
INTRODUCTION
Transdermal delivery has potential advantages over other routes of administration. It could reduce first-pass metabolism associated with oral delivery and is less painful than injections. However, the outermost layer of the skin, the stratum corneum (SC), limits passive diffusion to small lipophilic molecules. Therefore, methods are needed to safely permeabilize the SC so that ionic and larger molecules may be delivered transdermally [1]. Many techniques have been aimed to disrupt and weaken the highly organized intercellular lipids in an attempt to enhance drug transport across the intact skin. One of the most controversial methods is the use of vehicle formulations as skin delivery systems. Even though, some authors suggested that conventional lipid-based suspensions such as liposomes, niosomes, and micro-emulsions, which have also been proposed as low- risk drug carriers, do not offer much value in transdermal drug delivery because they do not deeply penetrate the skin, but rather remain on the upper layers of skin strata in addition to poor stability [2], researchers introduced modified forms of vesicular systems which exhibited better transdermal permeation and stability [3].
Ethosomes are noninvasive delivery carriers that enable drugs to reach the deep skin layers and/or the systemic circulation. These are soft, malleable vesicles tailored for enhanced delivery of active agents. They are composed mainly of phospholipids, high concentration of ethanol and water. Ethosomes are the best alternative to liposomes and transferosomes as ethanol overcome the problem of entering to SC by increasing penetration rate [4].
Vancomycin hydrochloride is a glycopeptide antibiotic used in the prophylaxis and treatment of infections caused by gram-positive bacteria [5]. Vancomycin is bactericidal by binding to the transglycosylase/transpeptidase complex of enzymes that are responsible for the last stages of bacterial cell wall formation [6]. Vancomycin is currently available in the market as parenteral infusion. The only indication for oral vancomycin therapy is in the treatment of pseudo membranous colitis. Inhaled vancomycin has also been used (off-label), via nebulizer, for treatment of various infections of the upper and lower respiratory tract [7].
Research work involves topical application of vancomycin was mainly restricted to the situation where the main permeation barrier is damaged as in cases of skin wounds and ulcers [8-10]. Some trials are found in order to examine the ability of some delivery system to transport vancomycin across intact biological barrier, where Jun [11] studied transdermal iontophoresis of vancomycin to infectious disease in orthopedics. The present work was focused on evaluating the potential of ethosomes in transdermal delivery of macromolecules, and to formulate a new delivery system of vancomycin drug capable of providing sustained and controlled release of the drug.
MATERIALS AND METHODS
Materials
Vancomycin hydrochloride was a gift from Sigma tec, Egypt. Soy phosphatidylcholine and Stearylamine were purchased from Sigma –Aldrich, USA. Potassium dihydrogen phosphate, Disodium hydrogen phosphate and Sodium chloride were purchased from El- Nasr Pharmaceutical Co., Egypt. All other reagents and solvents were of analytical grade.
Methods
Preparation of ethosomes
Vancomycin hydrochloride ethosomes was prepared by cold method [12]. The ethosomal system of vancomycin hydrochloride was comprised of 1–3 % w/v soy phospholipids (SPC), 30 – 45 % v/v of ethanol and water up to 100% v/v. SPC was dissolved in ethanol together with 250 mg of vancomycin hydrochloride. The mixture was heated to 30°C in water bath. Distilled water is added slowly in a fine stream with a constant mixing using mechanical stirrer, at 700 rpm in a closed vessel. The temperature was maintained at 30°C during the experiment. The mixing was continued for 5 minutes. Ethosomes suspensions were transferred to a 15 ml centrifuge tube. The suspension was centrifuged at 13,000 rpm for 1 hour at 4°C using a cooling centrifuge (Sigma 3K 30, Germany), then re suspended in PBS. The preparation was stored at 4°C.
Preparation of modified ethosomes
For the selected formula stearylamine (SA) in 0.4% and 0.8% or propylene glycol (PG) in 5 and 10% was added as shown in table (1). For PG formulae, a modified method was used where PG was added to distilled water before mixing with the organic phase. On the other hands, SA formulae, SA was mixed with SPC and dissolved in ethanol together with 250 mg of vancomycin hydrochloride before adding aqueous phase. The remaining steps of the preparation process were followed as mentioned above.
Characterization of ethosomes
Electron microscopy
Ethosomal vesicles were visualized using transmission electronic microscopy (Hitachi H-7500 80kVJapan), with an accelerating voltage of 80 kV.
Determination of entrapment efficiency (EE)
Vancomycin hydrochloride ethosomes suspensions were transferred to a 15 ml centrifuge tube. The suspension was centrifuged at 13,000 rpm for 1 hour at 4°C using a cooling centrifuge (Sigma 3K 30, Germany). Following centrifugation, the sediment was lysed using methanol and analyzed spectrophotometrically by measuring the U. V. absorbance at 280.20 nm using-U. V- Visible Spectrophotometer, Model UV- 1650 P. C (Shimaduzu, Japan).
The encapsulation or entrapment efficiency was determined relative to the original drug concentration added, applying the following equation.
%E=ED/TDX100
Where % E is the percent encapsulation efficiency, ED is the concentration of entrapped drug and TD is the total drug concentration.
Particle size analysis and Zeta potential measurement
The vesicle size and zeta potential was measured by Malvern zetasizer (V.6.010: Malvern instrument L. D. T Malvern UK)
In vitro skin permeation study
The in vitro skin permeation of vancomycin hydrochloride was studied using locally fabricated Franz’s diffusion cell with an effective permeation area and receptor cell volume of 3.14 cm2and 30 mL, respectively. The temperature of the receiver vehicle (PBS, pH 7.4) was maintained at 37±1°C and was constantly stirred by a magnetic stirrer at 100 rpm. The rat skin was subsequently carefully checked through a magnifying glass to ensure that samples were free from any surface irregularity such as tiny holes or services in the portion that was used for transdermal permeation studies. The skin was later mounted on a receptor compartment with the SC side facing toward the donor compartment. An amount of ethosomes equivalent to 150 mg of vancomycin hydrochloride was placed in the donor compartment. Samples of 0.5 ml were withdrawn from the receptor compartment every hour for 12 hour then immediately analyzed by UV spectrophotometer. The receptor phase was immediately replenished with equal volume of fresh diffusion buffer. Similar experiments were performed with PBS of pure drug sample.
Permeation data analysis
The permeation profile conducted by plotting the cumulative amount of permeated drug (μg/cm2) versus time (hr), the steady state flux Jss(μg/cm2. hr) was calculated from the slope of the linear portion, permeability coefficient [kp] was calculated by dividing [Jss] by the employed concentration of the drug (Co) according to the equation: Kp= Jss/ Co.
Microbiology study
The effect of incorporation vancomycin hydrochloride into ethosomal formulation upon the minimum inhibitory concentration was studied using critical dilution method and disc diffusion assay [13]. The disc, which is used in the experiment, was saturated with 15 µl. The count of staphylococcus aureus MRSA was 1.6 x 108 cfu/ml, the test was performed using Mueller-Hinton agar and the plates were incubated on 37ºC /24-48 h, the experiment was conducted in triplicate.
Stability studies
Stability studies were carried out by storing out the ethosomal formulation at 4ºC for 90 days. The drug content was estimated to identify any change in the entrapment efficiency of ethosomal formulae.
Statistical analysis of data
To investigate the significance difference between the results of studied formulae, the one way analysis of variance (ANOVA) test was used. The level of significance was set at α 0.05, and (*p<0.05) was considered to be statistically significant.
RESULTS AND DISCUSSION
Visualization of vesicles
Electron microscopy showed that ethosomes vesicles were unilameller and of a spherical shape as shown in fig. 1.

Fig. 1: Visualization of vesicles by transmission electron microscopy
Entrapment efficiency
Entrapment efficiency was found to increase with increasing ethanol concentration this may be related to co-solvent effect of ethanol; therefore, the more drug amount could be accommodated into the aqueous core of the vesicles. Increase in SPC concentration showed increase in drug entrapment as shown as in table (1). Addition of PG led to a significant decrease in entrapment efficiency. This is may be due to the poor solubility of vancomycin hydrochloride in PG [14], also this is may be attributed to the fact that increasing the concentration of permeation enhancer, the fluidity of bilayer also increased causing the drug to leach out of vesicles. Addition of SA a cationic surfactant led to a significant increase in entrapment efficiency. This result was attributed to the long stearyl chain (C18) inserted into the lipid bilayers which become tighter leading to decreasing the elasticity and increasing rigidity of vesicle and consequently lower permeability to the entrapped drug and hence, higher entrapment efficiency was observed.
Particle size analysis
The size of the vesicles was increased with increasing phospholipids concentration. This could be attributed to the fact that SPC confers greater rigidity to vesicle consequently reducing vesicle fusion. By increasing ethanol concentration the vesicular size decreased. This indicates that at higher ethanol concentration the membrane thickness is reduced considerably, probably due to the formation of a phase with interpenetrating hydrocarbon chain. These results are in agreement with previous research studies [15-17]. Incorporation of PG resulted in reduction in vesicle size. This suggests an interaction of PG with the phospholipid bilayer where the enhancer interpenetrates the SPC hydrocarbon chain allowing more bilayer flexibility and smaller vesicle size. Incorporation of SA led to significant increase in particle size. This may attributed to the fact that inclusion of surface charge inducer (SA) in the lipid bilayer increased the spacing between the bilayers and led to a rise of the internal aqueous compartment, also the charge inducer was found to enhance significantly the amount of drug entrapped into the vesicles. This result was in accordance with Nikoofal-Sahlabadi et al [18] who observed an increase in vesicle size upon addition of SA.
Zeta potential measurement
Zeta potential is an important parameter that affects the aggregation of vesicles and depicts the physical stability of vesicular systems. High zeta potential prevents the aggregation between vesicles and hence, enhances its physical stability [19]. Ethosomal formulae exhibited negative charge ranging from (-29.3 mv to- 53.1 mv).
The zeta potential value was increased by increasing SPC and ethanol concentration, this was attributed to (i) ethanol, which provides a net negative surface charge thus avoiding aggregation of vesicles due to electrostatic repulsion; and (ii) SPC, which provides a greater rigidity to the layers and reduced likelihood of vesicles fusion carry a negative charge likely due to ionization of phosphate group resulting in a high negative charge. Incorporation of PG resulted in higher zeta potential values.
This result agrees with Pandey [20] who concluded that PG induced a transition in the charge of the vesicles to more negative values. Incorporation of SA led to shift in the surface charge of the vesicles from negative charge to positive one. These results indicate the association of SA molecules at the vesicle surface.
Table 1: Composition, entrapment efficiency, average particle size and zeta potential of ethosomal formulae
| Formulae | SPC (%w/v) | Ethanol (%v/v) | SA (%w/v) | PG (%v/v) | EE±S. D (%) | Average vesicular size± S. D (nm) | Zeta potential ±S. D (mv) |
| F1 | 1 | 30 | - | - | 63.24±0.95 | 183.5±18.45 | -29.3±2.85 |
| F2 | 2 | 30 | - | - | 67.06±0.10 | 185.2 ±8.80 | -35.5±0.60 |
| F3 | 3 | 30 | - | - | 69.73±0.09 | 250.8±16.1 | -47.3±2.25 |
| F4 | 1 | 40 | - | - | 67.69±0.74 | 136.0±16.1 | -33.4±1.53 |
| F5 | 2 | 40 | - | - | 70.55±0.81 | 139.7±8.50 | -48.9±0.10 |
| F6 | 3 | 40 | - | - | 75.64±0.47 | 201.1±9.90 | -49.9±0.83 |
| F7 | 1 | 45 | - | - | 71.96±0.70 | 105.3±11.2 | -44.2±1.65 |
| F8 | 2 | 45 | - | - | 77.81±0.73 | 116.2±5.50 | -53.1±1.40 |
| F9 | 3 | 45 | - | - | 78.23±0.41 | 153.6±20.9 | -49.5±0.94 |
| F10 | 1 | 45 | 0.4 | - | 80.26±0.35 | 153.9±6.80 | +37.1±0.98 |
| F11 | 1 | 45 | 0.8 | - | 89.79±0.46 | 195.3±10.70 | +48.1±1.10 |
| F12 | 1 | 45 | - | 5 | 55.85±0.95 | 103.0±9.45 | -48.1±1.50 |
| F13 | 1 | 45 | - | 10 | 48.95±0.64 | 71.60±17.6 | -50.5±2.00 |
In-vitro permeation studies
The Transdermal penetration of vesicles is determined by vesicle size, where the penetration abilities of permeate are inversely related to the size of ethosomes and vesicles smaller than 300 nm are able to deliver the permeate into deeper skin layers efficiently, other factors affecting drug permeation from ethosomes are surface charge, elasticity and composition of vesicle bilayer. The value of transdermal flux depends on the ethanol concentration. As the concentration of ethanol increased, flux value of vancomycin hydrochloride increased. Formulae F2, F5and F 8 containing same percent of SPC 2% w/v whereas increasing ethanol concentration from 30 % v/v to 40 and 45%v/v respectively leading to enhancing transdermal flux from 169.8 ug/cm2/hr to195.3 ug/cm2/hr and 221.2 ug/cm2/hr. This result is supported by the observation of zidovudine-loaded ethosome made by Jain et al [21]. The data suggested that the transdermal flux of zidovudine increased with increasing ethanol concentration.
When SPC concentration increased, there was increase in drug permeation but when SPC concentration exceeded 2% w/v there was a subsequent decrease in permeation of vancomycin hydrochloride from ethosomes. These results indicate that if the percentage of SPC exceeded 2%w/v, bilayer deformability of vesicles occurred with subsequent reduction in permeation drug from ethosomes. This result is in accordance with Barupal et al [22] who found that when the percentage of SPC exceeded 2w/v% there was reduction in permeation of aceclofenac from ethosomes and attributed that to decrease in the bilayer deformability of vesicles.
In spite that skin is negatively charged under the physiological conditions and we assume that by imparting a positive charge on vesicles surface using SA that will enhance the drug permeation across the skin, unfortunately, vancomycin hydrochloride release decreased as the percentage incorporated of SA increased. The steady state flux of F7 was 222.1 ug/cm2/hr on adding 0.4% v/w SA (F10) the value is reduced to 192.1 ug/cm2/hr and further increase in SA percentage to be 0.8% w/v (F11) was followed by decrease in flux value to become 120.4 ug/cm2/hr. This result was attributed to the long stearyl chain inserted into the lipid bilayers that led to a lower permeability to the entrapped drug.
Addition of PG into composition of F7 in 5 and 10% v/v led to an increase in drug permeability through rat skin, where PG acts as permeation enhancer, which increases permeability of vesicle through biological membrane due to synergistic effect with ethanol on bilayer of the vesicles. In addition to increasing the deformability of vesicles, extraction of intercellular lipids, increasing SC hydration, alteration of proteinaceous corneocyte components. These results is in agreement with Zhaoa et al [23] who compared vesicles containing PG with traditional ethosomes and concluded that PG vesicles showed better transdermal efficiency than ethosomes.
Antimicrobial activity of free and ethosomal vancomycin hydrochloride
The minimum inhibitory concentration (MIC) of vancomycin hydrochloride loaded ethosomes compared with free antibiotics against staphylococcus aureus MRSA (ATCC43300) are shown in fig. (2and3) and table (3). Ethosomal formulae F12 and F13 showed MIC value equal to MIC of free drug. However, the cationic ethosomal formulae F10 and F11 yielded MIC value (2.44 µg/ml) lower than MIC obtained with the free drug. Such enhancement could be explained on the basis that, in cationic formulae adsorption of cationic vesicles onto bacterial cells changes the sign of the cell surface from negative to positive with a clear relationship between positive charge on bacterial cells and cell death.
Fig. 2: The effect of drug encapsulation into vesicular system on minimum inhibitory concentration of vancomycin hydrochloride
Table 2: Permeation parameters of vancomycin hydrochloride from different formulae through hairless rat skin
| Formulae | Cumulative amount at 12 hrs [Q12,(ug/cm2)] | Flux
[Jss,(ug/cm2/hr)] |
Permeability coefficient
[Kp,(cm/hr)] |
| Free drug | 85.33±0.99 | 5.706 | 0.000038 |
| F1 | 596.27±0.96 | 37.37 | 0.000249 |
| F2 | 1978.83±0.83 | 169.8 | 0.001126 |
| F3 | 337.09±0.94 | 20.57 | 0.000137 |
| F4 | 1010.11±0.76 | 50.94 | 0.000339 |
| F5 | 2516.9±0.89 | 195.3 | 0.001302 |
| F6 | 571.10 ±0.83 | 46.97 | 0.000313 |
| F7 | 2525.48±0.60 | 222.1 | 0.001480 |
| F8 | 2585.12±0.69 | 221.2 | 0.001474 |
| F9 | 2119.70±0.86 | 200.0 | 0.001333 |
| F10 | 2244.22 ±0.77 | 192.1 | 0.001280 |
| F11 | 1409.14±0.63 | 120.4 | 0.000802 |
| F12 | 3008.47±0.64 | 277.0 | 0.001846 |
| F13 | 4390.55±0.51 | 414.7 | 0.002764 |
Table 3: The minimum inhibitory concentration of free vancomycin hydrochloride and ethosomal formulae
| Formulae | MIC (µg/ml) |
| Free Drug | 4.88 |
| F10 | 2.44 |
| F11 | 2.44 |
| F12 | 4.88 |
| F13 | 4.88 |
This result is in agreement with Gubernator et al [24] who found that cationic formulations exhibit significantly higher bactericidal efficacy than anionic and neutral vesicles, regardless the type of drug and concluded that the MIC antimicrobial efficacy is not correlated to rapid drug release from vesicular system but rather to electrostatic interaction between the vesicle and bacterial cell.
Fig. 3: Disk diffusion method showing MIC of (a) free drug, (b) F10 and (c) F13
Stability
Table 4 and fig. (4) presented the effect of storage conditions on the amount of drug entrapped by the end of the study. Propylene glycol PG showed a promising effect on the stability of ethosomes. The percentage of entrapped drug in F13 was significantly increased than non-PG ethosomes F7. These results suggest a stabilizing effect of PG in the formulations against aggregation of vesicles by providing a net negative charge on their surface. These results were in agreement with Elmoslemany et al [25] who found that the drug leakage was more evident in conventional liposomes compared to the ones containing PG. On the other hand, SA exhibited an undesirable effect on stability of ethosomes as shown in F10. However, the encapsulated drug tends to leak out from the bilayer structure during storage in all formulations. This could be attributed to phospholipid leakage from the ethosomes bilayers which led to the formation of pores that increased drug leakage [26].
Table 4: Effect of storage for 90 days at refrigerated temperature of ethosomes on drug content
| Formulae | Initial concentration | % Residual drug content after storage for 90th days |
| F7 | 100 | 81.88±0.55 |
| F10 | 100 | 77. 67±1.20 |
| F13 | 100 | 89.82±1.00 |
Fig. 4: Effect of storage for 90 days at refrigerated temperature of ethosomes on drug content.
CONCLUSION
The results demonstrate that ethosomes is an efficient noninvasive tool for transdermal delivery of vancomycin hydrochloride, the entrapment efficiency, particle size and zeta potential values were mainly dependant on vesicular components. The addition of permeation enhancer PG to selected formula enhance the transdermal flux, reduce particle size, did not alter the MIC of drug and stabilize the formula against drug leakage on storage but reduce entrapment efficiency of drug, while the addition of cationic surfactant led to significant reduction in drug permeation, increase particle size and lesser drug retention on storage but surprisingly lowered the MIC compared to free drug and increase entrapment efficiency. The study is a platform in formulating delivery system capable of delivering vancomycin hydrochloride transdermally.
CONFLICT OF INTERESTS
Declared None
REFERENCES